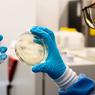

Sobota, 17. 11. 2018, 9.04
7 let
Cerar jamra: Izgubili smo eno leto, zdaj pa še 200 milijonov

Madžarski predsednik Viktor Orban se bo raje pogovarjal s Trstom.
Da Madžarska ne namerava sodelovati s Slovenijo pri gradnji drugega tira, je predsednika SMC in nekdanjega premierja Mira Cerarja negativno presenetilo. Namesto da bi danes že gradili, smo najprej izgubili eno leto zaradi referendumov, zdaj pa še 200 milijonov evrov, je dejal.
Napoved madžarskega premierja Viktorja Orbana, da Madžarska ne bo sodelovala pri gradnji drugega železniškega tira Divača-Koper in pri razvoju koprskega pristanišča, je zelo negativna novica za Slovenijo, je ob prihodu na vrh koalicije dejal Miro Cerar. "Zanjo pa smo si povsem sami krivi," je dodal.
Ob tem je obžaloval, da smo izgubili po njegovih besedah izjemno priložnost, da bi z madžarskim vlagateljem pri gradnji drugega tira prihranili 200 milijonov evrov in dobili kredibilnega partnerja pri infrastrukturnih povezavah ter na ta način pripomogli, da bi imela Luka Koper s Slovenskimi železnicami in drugimi gospodarskimi subjekti v prihodnje več dobička in več možnosti za poslovanje.
Madžarska je po Cerarjevih besedah izgubila potrpljenje s projektom zaradi nekaj naših nepremišljenih in nepotrebnih izjav. "V prejšnji vladi smo si tri leta močno prizadevali, da bi z Madžari sklenili strateško partnerstvo glede infrastrukture," je dejal Cerar.
Luka Koper je namreč za Madžarsko vitalnega pomena, s sodelovanjem pa bi tudi mi veliko zaslužili, je povedal. "Zdaj smo to priložnost izgubili," je obžaloval.
"Referendume spromoviral Vili Kovačič s pomočjo Janeza Janše"
Namesto da bi danes že gradili drugi tir, smo še vedno na mrtvi točki. Cerar je spomnil, da so projekt najprej za eno leto zaustavili referendumi, "ki jih je spromoviral Vili Kovačič s pomočjo Janeza Janše", zdaj pa smo izgubili še 200 milijonov evrov. "In resnično me skrbi, kam gre Slovenija, če bomo nadaljevali po tej poti," je dejal.
 Vprašanje financiranja drugega tira bo tako na zahtevo SMC tudi pomembna točka današnjega vrha koalicije, ki ga je premier Marjan Šarec sklical z namenom posveta o proračunu in pogajanjih z javnim sektorjem. "To vprašanje nameravam danes z vso resnostjo sprožiti na vrhu koalicije, kajti finančna konstrukcija za drugi tir je bila lepo zaprta, obetalo je, da bo to mogoče varno izpeljati, brez da bi prišlo do kakšnih neprijetnih presenečenj, zdaj pa me zanima, komu bomo vzeli," je poudaril Cerar.
Vprašanje financiranja drugega tira bo tako na zahtevo SMC tudi pomembna točka današnjega vrha koalicije, ki ga je premier Marjan Šarec sklical z namenom posveta o proračunu in pogajanjih z javnim sektorjem. "To vprašanje nameravam danes z vso resnostjo sprožiti na vrhu koalicije, kajti finančna konstrukcija za drugi tir je bila lepo zaprta, obetalo je, da bo to mogoče varno izpeljati, brez da bi prišlo do kakšnih neprijetnih presenečenj, zdaj pa me zanima, komu bomo vzeli," je poudaril Cerar.
Bratuškova: Z Madžarsko bi bil drugi tir še dražji
Ministrica za infrastrukturo Alenka Bratušek je zadovoljna z Orbanovo napovedjo, da njegova država ne bo sodelovala pri gradnji drugega tira. "Če bi gradili skupaj z Madžarsko, bi bil strošek gradnje proge Divača-Koper nekaj sto milijonov evrov dražji, kot če ga bomo zgradili sami," je dejala.
Bratuškova je ob prihodu na srečanje koalicijskih partnerjev spomnila, da je že septembra na zaslišanju za ministrico jasno povedala, kaj osebno misli o sodelovanju Madžarske pri financiranju drugega tira. Kot ministrica je nameravala predlagati, da Slovenija drugi tir zgradi sama, je pa še čakala na dokončne številke. Odločitev je sicer nameravala prepustiti vladi.
 Ob tem je k Orbanovi izjavi dodala oceno, da pod takšnimi pogoji, kot jih je zahtevala Madžarska, Orban v svojo državo nikoli ne bi pustil tujega investitorja.
Ob tem je k Orbanovi izjavi dodala oceno, da pod takšnimi pogoji, kot jih je zahtevala Madžarska, Orban v svojo državo nikoli ne bi pustil tujega investitorja.
Na vprašanje, kako bomo torej financirali ta projekt, je Bratuškova odgovorila, da se natančna finančna konstrukcija še pripravlja. Za zdaj še ni znano, ali bo treba zagotoviti dodatnih 200 milijonov evrov kapitala, ali pa bi tudi ta del lahko pokrili z zadolževanjem, je dejala.
Poudarila je, da zaradi odločitve Madžarske črpanje evropskih sredstev za ta projekt ni ogroženo, kar da je tudi sama preverila na pogovoru s komisarko Violeto Bulc. Glede posojila Evropske investicijske banke (EIB) pa je dejala, da dogovor še ni dokončen oziroma pogodba še ni podpisana. Predstavniki EIB so ji tudi zagotovili, da projekt brez Madžarske zanje ni težava oziroma da bi bil posel še lažje sklenjen.
Orban se je obrnil proti Trstu
Načrt, da bi Madžarska sodelovala pri gradnji drugega tira Koper-Divača in pri razvoju koprskega pristanišča, ne bo uresničen, je v petek na konferenci madžarske diaspore povedal Orban. Ob tem je po poročanju madžarske tiskovne agencije MTI razkril, da so v Budimpešti že začeli pogovore s Trstom.
S tržaškim pristaniščem, ki deluje po modelu, da pristanišče upravlja pristaniška uprava, ta pa pristaniško infrastrukturo z dolgoročnimi koncesijami oddaja v najem logistom, se bodo pogovarjali o dostopu do infrastrukture in o investicijskih priložnostih za madžarska podjetja, je dodal.
Orban je tako sodelovanje Madžarske pri drugem tiru očitno pokopal, še preden se je nova slovenska vlada odločila o nadaljevanju pogovorov z vzhodno sosedo, ki jih je začela Cerarjeva vlada in bila zaradi tega predmet kritik dela politike in javnosti.

Cerar trdil, da brez Madžarov ne bomo dobili nepovratnih sredstev
Glede 200 milijonov evrov Madžarske za drugi tir je bilo veliko nejasnosti. Cerarjeva vlada je trdila, da je njihova udeležba nujna za pridobitev evropskih nepovratnih sredstev, kar pa je pozneje zavrnila tudi evropska komisarka Violeta Bulc.
Dvome glede udeležbe Madžarske pri drugem tiru je imel v pogovoru za Siol.net tudi ekonomist Mojmir Mrak. "Da bi dali celoten projekt v soupravljanje za 200 milijonov evrov, je neresno," meni Mrak.
Manjkajoča sredstva 200 milijonov evrov bo Slovenija po besedah Metode Dragonja zagotovila iz proračuna.
Zagotovljenih 233 od načrtovanih 250 milijonov evropskih sredstev
 Finančna konstrukcija projekta drugega tira predvideva 200 milijonov evrov kapitalskega vložka Slovenije, 200 milijonov evrov kapitalskega vložka zalednih držav, 250 milijonov evrov evropskih sredstev in 311 milijonov evrov dolžniških virov financiranja, kamor spadajo krediti pri Evropski investicijski banki (EIB) ter Slovenski izvozni in razvojni banki (SID banka).
Finančna konstrukcija projekta drugega tira predvideva 200 milijonov evrov kapitalskega vložka Slovenije, 200 milijonov evrov kapitalskega vložka zalednih držav, 250 milijonov evrov evropskih sredstev in 311 milijonov evrov dolžniških virov financiranja, kamor spadajo krediti pri Evropski investicijski banki (EIB) ter Slovenski izvozni in razvojni banki (SID banka).
Kot smo že omenili, je Evropska komisija prek zgoraj omenjenega blending razpisa Sloveniji za gradnjo sedmih predorov na novi železniški progi Divača-Koper namenila 109 milijonov evrov. Osemdeset milijonov evrov za gradnjo osmega predora in dveh viaduktov si je država medtem zagotovila iz evropskega kohezijskega sklada.
Evropska komisija je projektu namenila tudi 44,3 milijona evrov nepovratnih sredstev za pripravljalna dela iz instrumenta Cef, kar pomeni, da si je država za omenjeni projekt zagotovila 233 od načrtovanih 250 milijonov evropskih sredstev.
Prav tako smo na Siol.net poročali, da naj bi Madžari v zameno za 200 milijonov evrov preigravali možnost vstopa v Luko Koper, sorazmerni delež madžarskega prevoznika Gysev pri tovornih prevozih med Koprom in Madžarsko, gradbene posle za madžarska gradbena podjetja ter okrepitev poslovnih povezav med Koprom in logističnim centrom, ki naj bi ga gradili pri Blatnem jezeru.
Orban hrvaške Reke ni omenjal
 Ni pa Orban kot alternative sodelovanju Madžarske pri drugem tiru in razvoju Luke Koper navedel hrvaške Reke, čeprav je bila ta v zgodovini glavno pristanišče Kraljevine Madžarske. Reko sicer omejujeta pomanjkljiva pristaniška in zaledna infrastruktura, vendar pa tudi tam prihaja do sprememb.
Ni pa Orban kot alternative sodelovanju Madžarske pri drugem tiru in razvoju Luke Koper navedel hrvaške Reke, čeprav je bila ta v zgodovini glavno pristanišče Kraljevine Madžarske. Reko sicer omejujeta pomanjkljiva pristaniška in zaledna infrastruktura, vendar pa tudi tam prihaja do sprememb.
Kot je ta teden poročal hrvaški časnik Jutarnji list, naj bi ladijski prevoznik Maersk Line, družba Jadranska vrata, ki upravlja kontejnerski terminal Brajdica, in železniški logist PPD transport kmalu podpisali pogodbo o skladiščenju in prevozih materiala in opreme za drugo tovarno baterij za električne avtomobile, ki jo južnokorejski Samsung gradi na Madžarskem.
Mesečno naj bi PPD transport v obdobju enega leta z vlaki na Madžarsko prepeljal 5280 ton materiala. Tedensko naj bi na Madžarsko z Reke odpeljal vlak s 55 kontejnerji, prvi že konec tega meseca. Projekt je trenutno v poskusni fazi in za zdaj naj bi logistika potekala brez težav.
Hrvati se pogovarjajo s Kitajci
Po pisanju Jutarnjega lista gre za zelo pomemben projekt za načrte reškega pristanišča, da postane vstopna točka za azijsko blago v srednjo in vzhodno Evropo ob pričakovani selitvi dela industrije iz Kitajske nazaj v Evropo.
Če se bodo načrti uresničili in bo tovora na terminalu Brajdica ter na terminalu Zagrebačka obala, ki naj bi bil zaključen v kratkem, dovolj, se bo izplačala tudi gradnja drugega tira železniške proge od meje z Madžarsko do Zagreba in na okoli milijardo evrov ocenjena investicija v posodobitev proge od Zagreba do Reke, še piše časnik. V luči tega vidi tudi nedavne pogovore vodilnih hrvaških politikov s Kitajsko glede zakupa površin na terminalu Zagrebačka obala.

28